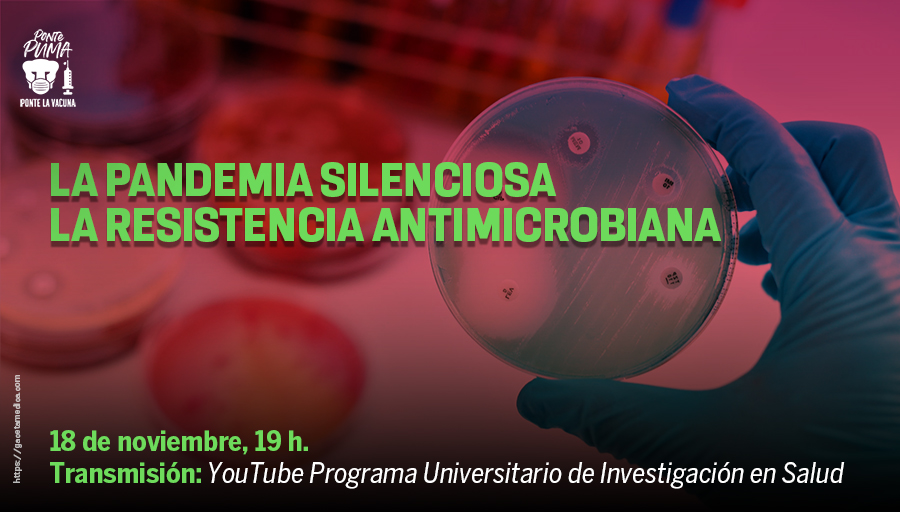
En la Semana Mundial de Concientización sobre el Uso de los Antimicrobianos, el @PUIS_UNAM transmitirá una serie de charlas en las que expertos abordarán el tema desde diferentes perspectivas &gt; bit.ly/3qlC3a8
#VacúnateYPonte😷

qbarido
@qbarido1
Cirujana comprometida con la seguridad del paciente -Lider en calidad de la atención quirúrgica y en la prevención de iinfecciones nosocomiales
ID: 1175160229086093312
20-09-2019 21:30:42
84 Tweet
72 Followers
45 Following




No está por demás recordar #YosiUsoCubrebocas #Sanadistancia amcgmx Saúl Ocampo González Mariel M Adriana Torres Juan Pablo Pantoja Abilene Escamilla qbarido Nayvi España Armelle Roberto Torres Jacobo @








El módulo 2 de nuestro Curso en línea: Metodología de la Investigación y Estadística Inferencial pronto dará inicio, conoce más entrando a nuestra página web o bien mándanos un correo a [email protected] puis.unam.mx/educacion_cont…


Totalmente de acuerdo . Con el apoyo de todos vamos a lograrlo #HeForShe #ILookLikeASurgeon amcgmx Aloha Meave MD Mariel M Ale Armengol qbarido lucy rivas Julia Hdez. Jerónimo Adriana Chaparro ADRIANA JOSEPHINE JAUREGUI Armelle

¿Qué está pasando con el turismo? ¿Se esta reactivando este sector? ¿Qué restricciones se enfrentan los viajeros? Hoy en #Hipócrates20: Viajes y vacunas en pandemia Con el Dr. Jorge Baruch Díaz (Baruch Díaz, MD MSc), de Clínica del Viajero ¡No faltes! Como cada martes a las 18h en Radio UNAM


Gracias FEMECOT A.C. por la invitación a participar con la ponencia ¿Como debemos comunicar el Evento Adverso? . Siempre cerca de Ustedes : Refrendó mi compromiso para apoyarlos en sus nutridas sesiones . Una audiencia de más de 500 asistentes #PracticaSegura




“Nuestra intención es llamar a atención sobre la Resistencia Antimicrobiana; ante la presentación silenciosa que tiene el problema” Samuel Ponce de Leon Abrimos hilo de la conferencia de prensa de La Pandemia Silenciosa: La Resistencia Antimicrobiana youtu.be/hdSP3yJ1umU